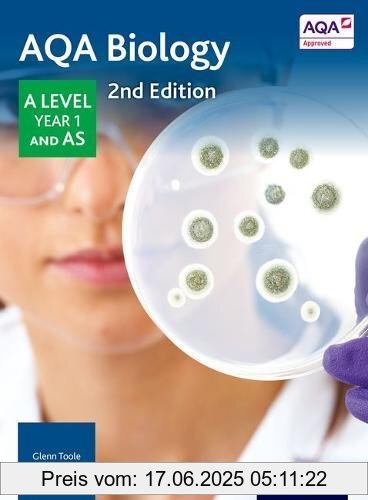
Binding : Taschenbuch, Edition : 2nd UK ed., Label : Oxford University Press, Publisher : Oxford University Press, NumberOfItems : 2, medium : Taschenbuch, numberOfPages : 328, publicationDate : 2015-01-08, authors : Glenn Toole, ISBN : 0198351763

Aqa Biology a Level Year 1 Student Book
10.99 €
Binding : Taschenbuch, Edition : 2nd UK ed., Label : Oxford University Press, Publisher : Oxford University Press, NumberOfItems : 2, medium : Taschenbuch, numberOfPages : 328, publicationDate : 2015-01-08, authors : Glenn Toole, ISBN : 0198351763
Adresse: Lange Str. 11, 59302 Oelde | Mobil Nr +4915752621307 | Ab Aug 25 |
Bücher von Oelder Buchhandel Lange Str. 11, 59302 Oelde 2025-06-17 05:11:22